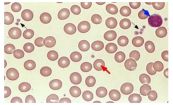
Phết máu ngoại biên - Quy trình thực hiện và những lưu ý cần biết

Viêm hạch mạc treo là tình trạng viêm các hạch bạch huyết ở mạc treo của ruột. Mạc treo là nơi kết nối ruột và thành bụng. Vậy bệnh lý này có nguy hiểm không? Cách chẩn đoán và chữa trị bệnh nào hiệu quả? Bài viết dưới đây sẽ giải đáp những thắc mắc này, mời các bạn tham khảo!

Viêm hạch bạch huyết mãn tính là tình trạng viêm hoặc nhiễm trùng hạch bạch huyết trong một thời gian dài. Tìm hiểu nguyên nhân, triệu chứng và phương pháp điều trị bệnh hiệu quả với bài viết dưới đây.

Xét nghiệm bệnh bạch cầu đơn nhân là những xét nghiệm máu để tìm kiếm các kháng thể của bệnh bạch cầu đơn nhân gây ra bởi vi-rút Epstein-Barr (EBV). Các kháng thể này được tạo nên bởi hệ thông miễn dịch của bạn để chống lại nhiễm trùng. Để hiểu rõ hơn về thủ thuật này, mời các bạn tham khảo bài viết dưới đây!

Viêm hạch bạch huyết thường là kết quả của bệnh nhiễm trùng cấp tính do liên cầu trùng, có thể gây ảnh hưởng tính mạng nếu không được chẩn đoán và điều trị. Để hiểu rõ hơn về bệnh lý này, mời các bạn tham khảo bài viết dưới đây!

Bệnh Porphyria là một nhóm các rối loạn máu di truyền hiếm gặp đặc trưng bởi việc không có khả năng tạo ra phân tử heme đúng cách (heme là một thành phần của hemoglobin). Phân tử heme tạo thành từ hai thành phần: porphyrin và sắt. Heme đóng vai trò quan trọng trong việc vận chuyển oxy và tạo ra các tế bào hồng cầu mang oxy. Heme cũng được tìm thấy trong myoglobin – một loại protein trong tim và cơ xương. Để hiểu rõ hơn về bệnh lý này, mời bạn đọc tiếp bài viết sau đây.

Rối loạn mỡ máu là tình trạng nồng độ lipid trong máu quá cao hoặc quá thấp. Lipid là các chất béo, bao gồm triglyceride và cholesterol. Nhiều người thường duy trì mức lipid lành mạnh bằng cách ăn uống cân bằng và có lối sống lành mạnh. Tuy nhiên, trong một số trường hợp, bác sĩ có thể chỉ định thêm một số thuốc để điều trị rối loạn mỡ máu. Dưới đây là bài viết chi tiết về bệnh, mời các bạn tham khảo!

Nhiễm trùng máu là một tình trạng sức khỏe nguy hiểm và có thể dẫn đến các biến chứng nghiêm trọng nếu không được điều trị. Vậy bệnh nhiễm trùng máu là gì? Nhiễm trùng máu có chữa được không? Tất cả sẽ được giải thích qua bài viết sau đây.

Với các nhóm máu, kháng nguyên hệ ABO và yếu tố Rh có thể được tìm thấy trong máu của người hiến máu và của người có khả năng nhận máu. Xét nghiệm này cũng dùng để xác định nhóm máu của thai phụ và trẻ sơ sinh. Để hiểu rõ hơn về thủ thuật này, mời các bạn tham khảo bài viết dưới đây.

Có nhiều vấn đề sức khỏe tiềm ẩn có thể gây nôn ra máu. Nếu không được thăm khám kịp thời, người bệnh có thể gặp nhiều biến chứng nguy hiểm. Để hiểu rõ hơn về bệnh lý này, mời các bạn tham khảo bài viết dưới đây.

Xát nghiệm nồng độ canxi trong máu sẽ giúp ta biết được lượng canxi nằm trong cơ thể là bao nhiêu (ngoại trừ phần canxi trong xương). Canxi là khoáng chất thường thấy nhất trong cơ thể người và cũng là một trong những khoáng chất có vai trò quan trọng nhất với chúng ta. Để hiểu rõ hơn về bệnh lý này, mời các bạn tham khảo bài viết dưới đây.

Xét nghiệm cortisol trong máu sử dụng một mẫu máu để đo nồng độ của cortisol trong máu của bạn. Cortisol là một hormone steroid do tuyến thượng thận tiết ra. Các tuyến thượng thận nằm phía trên quả thận của bạn. Người ta còn gọi đây là xét nghiệm cortisol trong huyết thanh. Để hiểu rõ hơn về thủ thuật này, mời các bạn tham khảo bài viết dưới đây.

Xét nghiệm nồng độ cotinine nhằm kiểm tra nồng độ cotinine trong máu. Từ “cotinine” thật ra là một phép đảo chữ của “nicotine”. Cotinine được hình thành khi nicotine bị chuyển hóa bởi quá trình oxy hóa. Cotinine có chu kỳ bán rã trong cơ thể khoảng 20 giờ và thường có thể phát hiện trong vài ngày đến 1 tuần sau khi hút thuốc lá. Để hiểu rõ hơn về thủ thuật này, mời các bạn tham khảo bài viết dưới đây.
Kỹ thuật phết máu ngoại vi được áp dụng để phát hiện các bệnh liên quan đến máu, đặc biệt là tình trạng thiếu máu, được thực hiện bằng cách quan sát các tế bào máu dưới kính hiển vi để có thể thấy được kích thước, hình dạng, màu sắc hoặc cấu tạo của tế bào hồng cầu. Để hiểu rõ hơn về kĩ thuật này, mời các bạn tham khảo bài viết dưới đây.

Xét nghiệm photphatase kiềm (ALP) là xét nghiệm nhằm kiểm tra nồng độ enzym ALP trong máu. Trị số bình thường của ALP rất thay đổi và khác nhau giữa mỗi người, chủ yếu là phụ thuộc vào tuổi tác, nhóm máu và giới tính. Cùng eLib.VN tìm hiểu bài viết dưới đây để hiểu rõ hơn về thủ thuật này.

Phù bạch mạch có biểu hiện phù hai tay, chân hoặc cả tay và chân. Đây là hậu quả của việc bạch huyết kém lưu thông do bị tắc nghẽn, bị tổn thương hoặc do các mạch bạch huyết phát triển không bình thường. Phù bạch mạch ở chân đôi khi được gọi là bệnh phù chân voi vì chân phù lớn như bàn chân voi. Cùng eLib.VN tìm hiểu bài viết dưới đây để hiểu rõ hơn nhé!

Bệnh phù chân voi là tình trạng các bộ phận cơ thể như chân, tay và bộ phận sinh dục sưng to quá mức. Triệu chứng của bệnh là chân sưng to như chân voi. Để hiểu rõ hơn về bệnh, mời các bạn tham khảo bài viết sau đây.

Xét nghiệm sàng lọc sinh hóa máu là xét nghiệm máu đo nồng độ một vài chất trong máu. Sinh hoá máu cho bác sĩ biết tình trạng sức khoẻ, tìm kiếm những vấn đề nhất định, và giúp nhận ra phương pháp điệu trị có hiệu quả hay không. Cùng eLib.VN tìm hiểu bài viết dưới đây để hiểu rõ hơn về thue thuật này nhé!

Thiếu máu tán huyết di truyền gồm một nhóm các rối loạn trong đó các tế bào hồng cầu của người bị bệnh có hiện tượng “tán huyết” (bị vỡ sớm), dẫn đến thiếu máu. Tham khảo bài viết ngay sau đây để hiểu rõ hơn về bệnh lý này nhé!

Thiếu máu nguyên bào sắt không đáp ứng với pyridoxine tính trạng lặn là một rối loạn về máu do di truyền đặc trưng bởi tủy xương bị suy, do đó không có khả năng sản xuất các tế bào hồng cầu một cách bình thường. Cùng eLib.VN tìm hiểu bài viết dưới đây để hiểu rõ hơn về bệnh lý này nhé!

Thiếu máu mãn tính, còn gọi thiếu máu do bệnh mãn tính, là kết quả khi các bệnh mãn tính ảnh hưởng đến khả năng tạo tế bào máu của cơ thể. Để hiểu rõ hơn về bệnh lý này, mời các bạn tham khảo bài viết dưới đây.